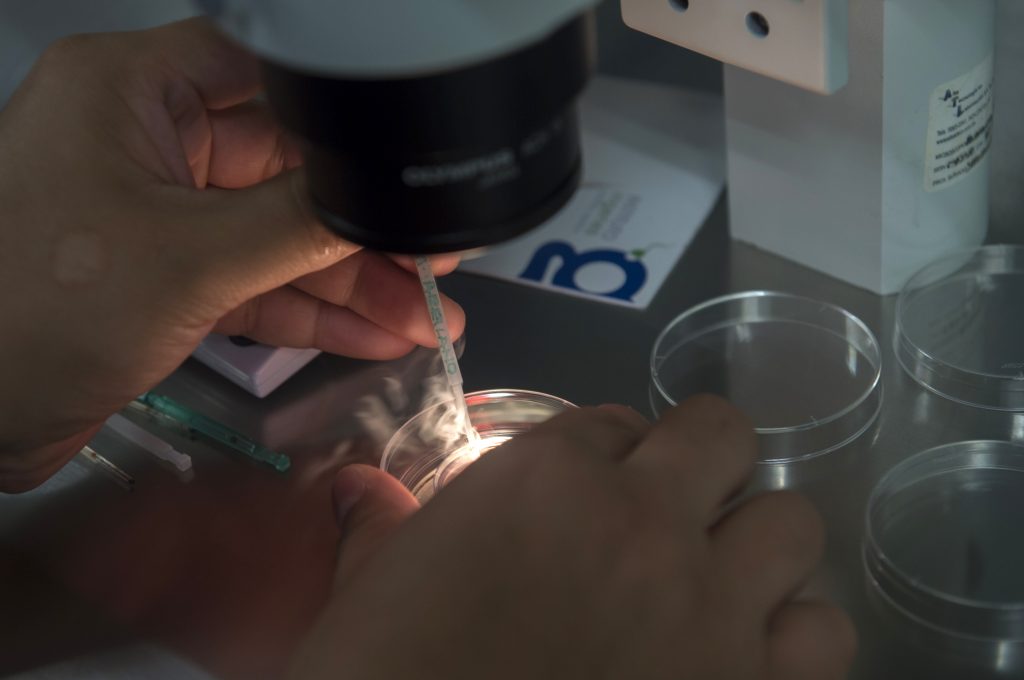

Ingenes es el Instituto de Reproducción Asistida líder en Latinoamérica, gracias a que cuenta con la tasa de casos de éxito más alta, con más de 50 mil bebés nacidos.
Hay más de una razón por la que Ingenes es la mejor opción para tener a tu bebé, pero sin duda la más importante es que estamos comprometidos a ayudarte a convertirte en mamá.
Las principales razones
Tenemos más de 15 años de experiencia y hemos encontrado la solución para lo que parecía imposible.
- Líderes de la industria ↗️
Nuestra tasa de nacimientos vía Fertilización In Vitro con óvulos propios es 10% más alta que la de otras clínicas en Estados Unidos y 78% más alta que el promedio de clínicas certificadas por la Red LARA, y nuestra tasa de In Vitro utilizando óvulos donados es 58% más alta que el promedio en Latinoamérica.
2. Nuestras instalaciones están diseñadas para tu comodidad y éxito 🏨
Contamos con el mejor equipo para brindarte la atención que mereces. Oficinas, consultorios y saldas de espera que garantizan lo mejor para nuestros pacientes.
3. Garantizamos un verdadero y efectivo Programa Evaluación 🩺
Todas las pacientes que nos visitan consiguen un diagnóstico adecuado, claro y confiable sobre lo que les está impidiendo embarazarse, así como también un trato personalizado desde la primera visita con nuestros expertos en Reproducción Asistida.
4. El mejor expertise en fertilidad y genética 👨⚕️👩⚕️
Capacitamos a los mejores expertos en Reproducción Asistida en nuestro Instituto y desarrollamos programas de investigación y de difusión del conocimiento en el área de fertilidad y genética, lo que nos coloca internacionalmente a la vanguardia.
5. Nuestras certificaciones 👨🎓
Estamos certificados por el Comité Internacional del Monitoreo de Tecnologías de Reproducción Asistida (ICMART) porque sin duda ofrecemos la mejor tecnología para tu planeación familiar y tu información está segura con nosotros, además, también contamos con el “Sello Dorado” de la Red de Reproducción Asistida de Latinoamérica (LARA Network), gracias a que nuestro liderazgo en innovación científica y tecnológica dentro del sector de tratamientos de infertilidad.
Tu sueño… en las mejores manos 🙌
Cada miembro de nuestro equipo está cuidadosamente seleccionado para tener los mejores resultados para ti, nuestro equipo multidisciplinario de especialistas en Reproducción Asistida, como biólogos, embriólogos, andrólogos, enfermeras, genetistas, etc., está a cargo de llevar a cabo las pruebas necesarias para analizar cada caso y elegir el mejor tratamiento para cada paciente, desde la primera consulta.
Además, el Instituto continúa investigando y capacitando expertos para desarrollar programas que resuelvan los problemas actuales de fertilidad.
Garantías y resultados 👍
Tener tu estrella en casa, quizá ha sido un largo camino, uno de muchos intentos, y esa es la principal razón para estructurar nuestros programas, porque entendemos lo que conlleva y haremos todo lo posible para garantizar el resultado que esperas.
En Ingenes, un tratamiento de Fertilización In Vitro podría incluir varias transferencias de embriones, dependiendo de la calidad de los que podamos reservar para ti, aumentando las posibilidades de lograr un embarazo.
Nuestros programas multiciclo Your Star at Home te brindan hasta 4 oportunidades de lograr un embarazo🤰, lo que garantiza evitar o reducir el desgaste emocional y económico para tener a tu bebé, pero no sólo eso, también tenemos una garantía donde te devolvemos tu dinero si tu bebé no llega a casa al finalizar tu tratamiento.
El primer paso siempre es muy importante, considera todas tus opciones y alternativas para que conozcas cada detalle sobre el camino que elegiste para obtener el mejor resultado.
Algunos sueños tienen un largo camino por delante, pero en Ingenes ese camino es una aventura, convertirte en madre es más que una gran decisión, déjanos ayudarte a lograrlo.
Acércate a Ingenes para descubrir juntos la mejor solución para tener a tu bebé 👶